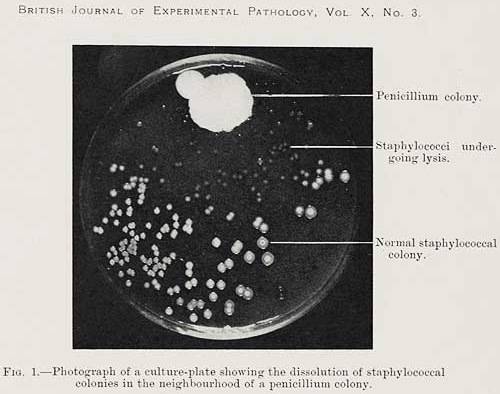

Nonviolenza
di Dante Fasciolo

-Tu lo conosci questo politico che non sta un minuto zitto e imperversa in tutte le televisioni a tutte le ore ??
-Si lo conosco, ha assoggettato tutti i direttori di reteTV...ma non andrà lontano...non sa più cosa dire...

-Eccomi sono il primo negli ascolti, il primo nei sondaggi...il più bravo...ho sempre ragione io....
(poverino non ha ancora letto la vignetta che lo precede)
Pronta la Poltrona in Campidoglio
per il nuovo Sindaco di Roma

25-9 - Giornata dei Sogni
26-9 - Giornata delle Lingue,
degli amanti dei Cani,
eliminazione delle Armi Nucleari
27-9 - Giornata del Turismo
28-9 - Giornata contro la Rabbia,
giornata del Sordo
29-9 - Giornata del Cuore
30-9 - Giornata Marittima
1-10 - Giornata Persone Anziane
2-10 - Giornata della Nonviolenza
3-10 - Giornata dell’Habitat
4-10 - Giornata degli Animali
5-10 - Giornata degli Insegnanti
7-10 - Giornata del Soccorso
in neretto: leggere articoli e l'editoriale
27 settembre 1943
Iniziano le Quattro giornate di Napoli

28 settembre 1928
Fleming scopre la penicillina
29 settembre 1944
Strage nazista di Marzabotto

2 ottobre 1869
Nasce Gandhi

3 ottobre 1990
Le due Germanie si riuniscono

4 ottobre 1957
Primo satellite nello spazio


Direi che il primo punto da stabilire è il budget, parola odiosa ma sempre al primo posto in quasi tutte le nostre scelte di vita. Stabilito quanti euro si possono spendere la scelta può essere per un paio di marche fino a qualche decina di altre marche e modelli, man mano che il budget si restringe.

La Mirra è un arbusto o piccolo albero nativo della penisola Arabica (Oman, Yemen) e dell’Africa (Gibuti, Etiopia, Somalia, Kenya nordorientale). Il suo habitat è quello delle formazioni della boscaglia del deserto ad altitudine di 250-1300 m, con una piovosità di 230-300 mm, principalmente in aree con suolo calcareo.

Il sacro e il profano. Eros e Thanatos. Ma questa rassegna ha anche l’ambizione di tradurre in immagini in movimento da una parte i nostri sogni infantili nati sulle pagine di qualche libro illustrato del bel tempo che fu – chi di noi non ha sognato di essere un coraggioso ed errante cavaliere?!

E’ un privilegio e una benedizione tornare ai nostri amati personaggi: questo ci permetterà di approfondire i più grandi misteri e gli scandali del loro mondo. Parkhurst sta per diventare veramente caotica”. Nella seconda serie Pulen e Fikile si ritroveranno e le conseguenze dell’ incontro saranno esplosive, mentre intorno a loro affioreranno nuovi misteri e colpi di scena.

Renato Cialente, nato a Treviglio, il 2 febbraio 1897; esordì in palcoscenico quindicenne, in Svizzera, e sottoposto al vaglio del grande Ermete Zacconi fu accolto nella sua compagnia: ma la prima guerra mondiale lo strappò al teatro per portarlo al fronte. Tornò a recitare nel 1921, come primo attor giovane nella compagnia di Annibale Betrone, passando nel ’24 in quella di Tatiana Pavlova, dove apprese come una religione il metodo Stanislavskij e interpretò con successo personaggi di Molnár, Arcybašev, Dostoevskij, Gogol e Pirandello.

Scoperto all’inizio del secolo scorso, è stato cacciato per la sua stupenda pelliccia e ancora oggi è vittima del bracconaggio, non solo per il vello ma anche per le parti del corpo che, come avviene per gli altri grandi felini, sono molto richiesti dalla medicina tradizionale cinese.

La Sambucina all’interno del Regno di Sicilia ha rappresentato il fulcro da dove si estese tutto il monachesimo latino e arrivò con le sue filiazioni partendo dalla valle del Crati, sino in Sicilia, in Basilicata ed in Puglia.
Casa madre dell’ordine Cistercense nel Regno di Sicilia fondò diverse filiazioni, divulgò l’architettura ogivale e con i suoi “magister” profuse tutte le conoscenze dell’ordine nel campo dell’architettura costruendo chiese, monasteri e acquedotti.


Ecco allora i frantoi ipogei, sorta di città sotterranee e parallele, grotte naturali o scavate nella pietra per produrvi l’olio. Cominciando il viaggio salentino, vivi già quel candore del silenzio, soprattutto nella borghese Presicce, espressione del passaggio dalla vecchia aristocrazia alla borghesia economica. Anche a Specchia rimane intatta l’armonia esteriore delle forme.

Cercando di essere fedeli alla visione di Mayenburg per cui “il teatro dovrebbe essere un luogo in cui non sentirsi al sicuro”, con Peng si costruisce un’atroce metafora politica, un'indagine drammatica sulla nascita di una nuova generazione di uomini forti, leader politici pregni d’amore incondizionato per le proprie nazioni, capaci di dare risposte molto semplici a problemi incredibilmente complessi.

Ancora il mese di Giugno 1959, 4 giorni con Pasolini che continua il suo viaggio senza soluzione di continuità - nel giro di 5 pagine - finisce il primo capitolo passando dalla Versilia alla Costa Maremmana fino all’Argentario con Porto Santo Stefano.

Gli elettori, in libertà ed autonomia, sono chiamati ad un compito importante, quali cittadini che devono scegliere i propri rappresentanti comunali , e questo vale per gli oltre mille comuni coinvolti nell’appuntamento del 3 e 4 ottobre, da Roma a Milano da Napoli a Bologna,a Torino, a tante altre città : al di là dei sondaggi, essi entrano nel seggio per esercitarvi il diritto-dovere del voto.

Le rovine della “città rossa”, la fortezza che ha resistito a Tamerlano, sono ancora imponenti e dominano il villaggio. La gente della tribù hazara sorride e saluta. Ha i tratti mongoli ereditati dalle orde che Gengis Khan spingeva lungo queste valli al centro dell’Afghanistan alla conquista della Persia.

La ciclista nel suo affannato percorrere, vestiva abiti da uomo, e qui ci furono ulteriori proteste contro di lei. Anche la stampa le si avventò contro definendola, al pari di una lesbica o di un eunuco. La sua capacità di esporsi nonostante tutto le attirò le prime simpatie di certa stampa, e qui fioccarono le prime interviste impostate tutte a suo favore, e Annie da donna ormai “navigata”, creò le sue “merchandises”.

Il pittore ama giocare con i riflessi che l’acqua lascia su una piazza, una strada o in un parco. I colori ne escono rinvigoriti e una tavolozza calda e familiare comunica una Mantova tranquilla, dove la vita scorre con i ritmi del passato e le persone affollano le strade o rimangono sole attraversando una piazza.

Artista concettuale, famoso per le sue “grattugie” in cui materia e colore portano un messaggio contemporaneo: la grattugia da comunissimo utensile presente in tutte le case diventa elemento centrale di una composizione complessa. Ogni opera è metafora della vita umana quotidiana, racconta storie, disagi, emozioni in una sorta di graffiante film della vita.

Ahi Genovesi, razza de superbi,
senza ‘na morale, pieni de vizzi,
dovessivo uscí fora dar monno.

Nuove iniziative per la XIII edizione del Reate Festival che a una ricca programmazione concertistica e di teatro musicale aggiunge quest’anno una serie di attività rivolte alla formazione oltre che alla promozione dei giovani artisti. Da settembre, e fino al 31 ottobre, la seconda edizione del Concorso internazionale di interpretazione di musica contemporanea a cui si aggiungono Masterclass di canto...

...i duellanti di partito dopo qualche minuto di dialogo protocollare, immancabilmente, si avviano a perdere coscienza del proprio ruolo istituzionale e – cosa davvero buffa - durante la lunga sincope che ne consegue c’è chi immagina di essere un tenore, chi un pollo da cortile, chi un mercante di piazza, chi la sirena di un sistema d’allarme...

Una piccola antologia del Santo attraverso una serie di vignette per ricordare la semplicità e la serenità della sua vita.